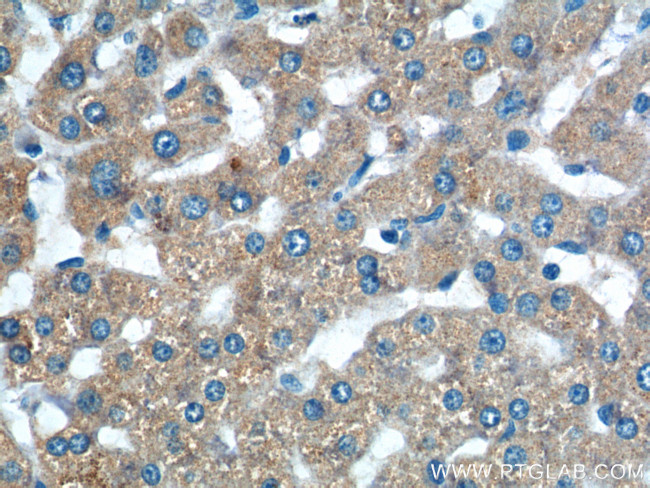
TAOK3 Antibody in Immunohistochemistry (Paraffin) (IHC (P))

Search
Proteintech
TAOK3 Polyclonal Antibody
{{$productOrderCtrl.translations['antibody.pdp.commerceCard.promotion.promotions']}}
{{$productOrderCtrl.translations['antibody.pdp.commerceCard.promotion.viewpromo']}}
{{$productOrderCtrl.translations['antibody.pdp.commerceCard.promotion.promocode']}}: {{promo.promoCode}} {{promo.promoTitle}} {{promo.promoDescription}}. {{$productOrderCtrl.translations['antibody.pdp.commerceCard.promotion.learnmore']}}
产品信息
10158-2-AP
宿主/亚型
分类
类型
抗原
偶联物
形式
浓度
规格
保存条件
运输条件
产品详细信息
Immunogen sequence: MRKGVLKDP EIADLFYKDD PEELFIGLHE IGHGSFGAVY FATNAHTSEV VAIKKMSYSG KQTHEKWQDI LKEVKFLRQL KHPNTIEYKG CYLKEHTAWL VMEYCLGSAS DLLEVHKKPL QEVEIAAITH GALHGLAYLH SHALIHRDIK AGNILLTEPG QVKLADFGSA SMASPANSFV GTPYWMAPEV ILAMDEGQYD GKVDIWSLGI TCIELAERKP PLFNMNAMSA LYHIAQNDSP T (1-240 aa encoded by BC002756)
靶标信息
TAOK3 (JIK) is a serine/threonine kinase that is a member of the GCK-like subfamily of the STE20 kinase family. JIK is ubiquitously expressed in human tissues, inhibits JNK and has been implicated in cancer.
仅用于科研。不用于诊断过程。未经明确授权不得转售。